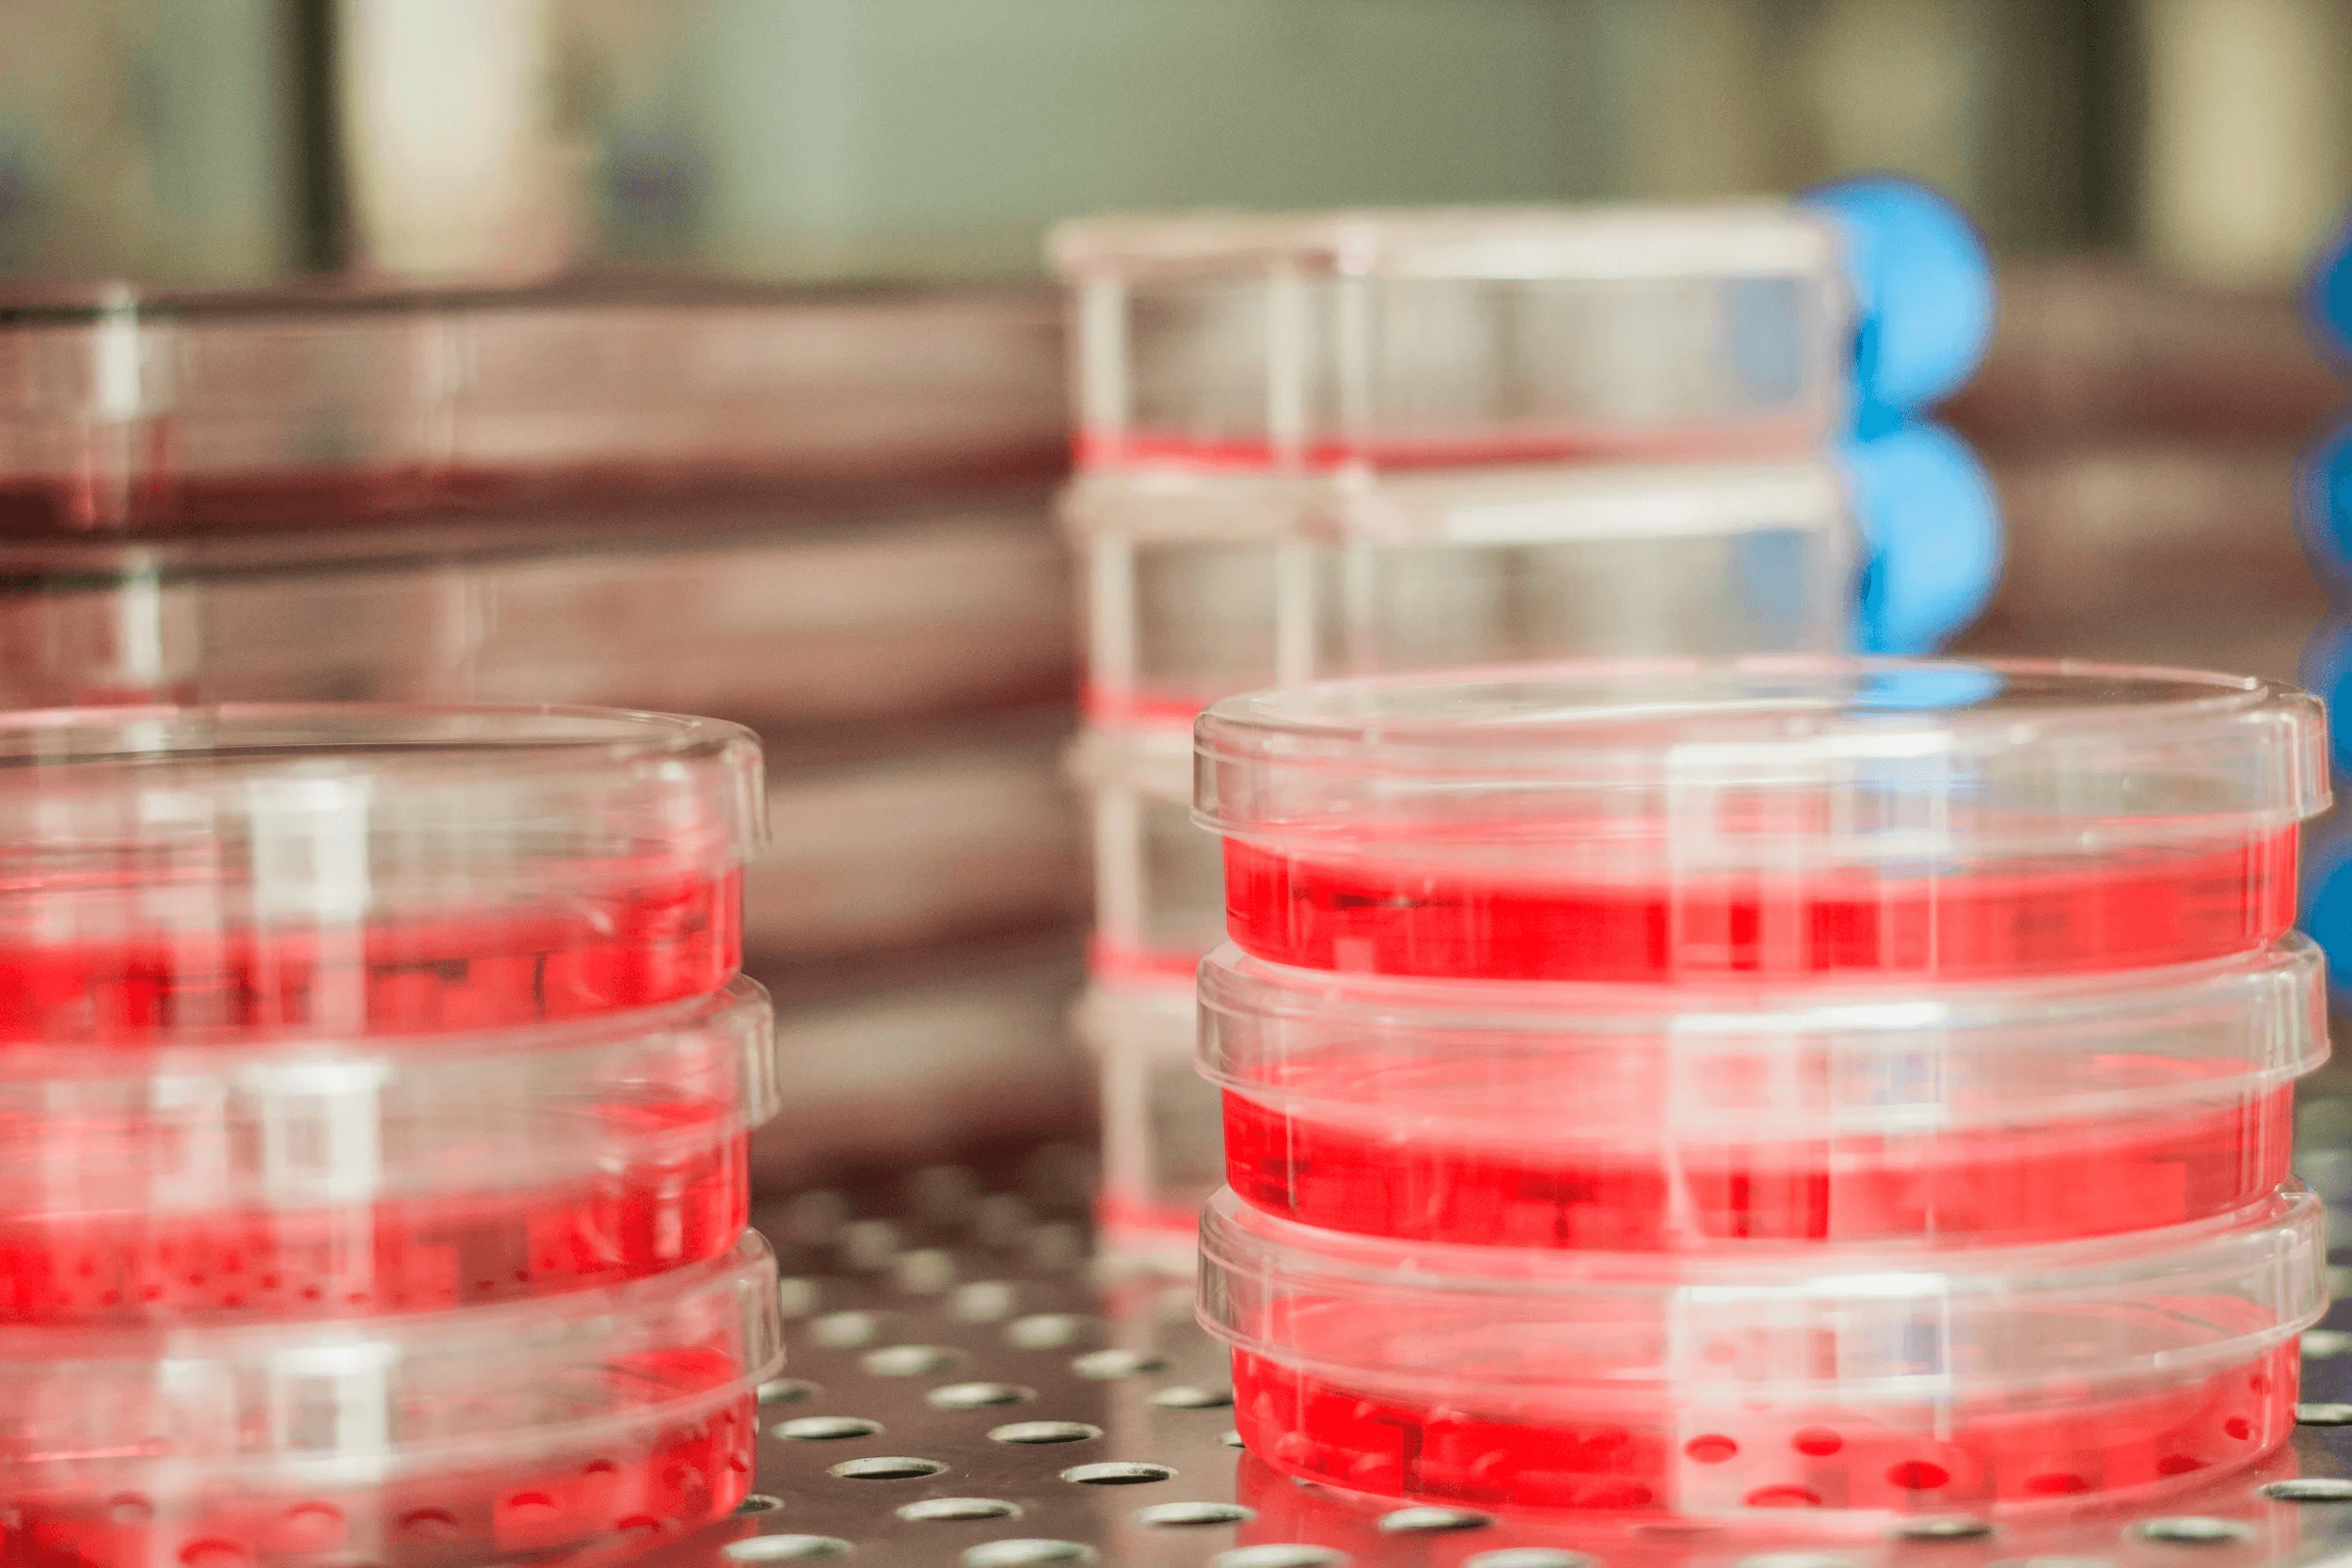
Cellular Engineering Laboratory (CEL) (Current)

Research
Cellular Engineering Laboratory (CEL) (Current)
Columbia University
We study how both physical and chemical forces affect cells and tissues, allowing us to engineer tissues for clinical applications. My current work focuses on cellular and biomaterial engineering solutions to osteoarthritis and other degenerative diseases in the knee

Shu Yang Group (Alumnus)
University of Pennsylvania
We develop sustainable soft materials and composites across nano-to-macro scales by combining chemistry, fabrication, and external stimuli. I focused on modifying the properties of liquid crystal elastomers using additives.